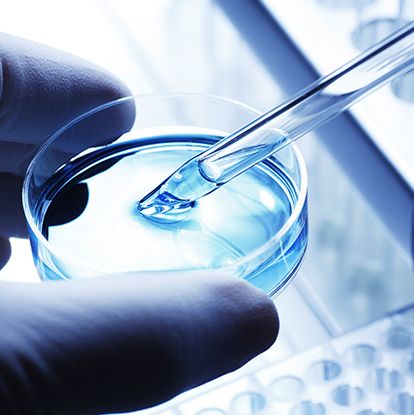
细胞库分析服务

动物疾病造模以及整体课题外部服务
一、动物实验 1、肿瘤相关疾病动物模型 2、 泌尿系统疾病动物模型 3、消化系统疾病动物模型 4、生殖系统疾病动物模型 5、神经系统疾病动物模型 6、 运动系统疾病动物模型等 二、 体外药理学(细胞毒性、体外药效等) 1、细胞生物学 2、 细胞增殖试验 3、 Q-PCR、WB、E
地区:苏州服务名称:动物疾病造模以及整体课题外部服务
询价

生产型高表达稳定细胞株构建-稳转细胞株构建
生产型高表达稳定细胞株构建 与瞬时转染不同,稳定细胞株构建是指外源基因进入受体细胞并整合到细胞的染色体上,使宿主细胞可长期表达目的基因。稳定细胞株有诸多用途,如蛋白抗体生产,信号传导、药物靶点研究,免疫治疗药物开发等,其表达的蛋白/抗体稳定性更好和批次差异性更小。 德泰生物提供高
地区:南京市江北新区浦乌北路11号服务名称:生产型高表达稳定细胞株构建
询价

多重免疫荧光技术服务
米徕迪提供多重免疫荧光技术服务,从制片--多重荧光染色--全景荧光扫描--图像定量与空间分析的全流程一站式技术服务。 实验使用新TSA荧光染色试剂盒,基于酪胺信号放大(Tyramide signal amplification,TSA)技术,可在一张组织切片样本上同时标记多个靶标
地区:南京服务名称:多重免疫荧光技术服务
询价

动物活体成像 分子影像
分子影像是运用影像学手段显示组织水平、细胞和亚细胞水平的特定分子,反映活体状态下分子水平变化,对其生物学行为在影像方面进行定性和定量研究的科学。 分子影像技术与传统方法比较主要优点是能够通过足够的时间和空间分辨率呈现完整生物个体,研究体内生物作用过程,除此之外分子影像能对同一个体
地区:江苏服务名称:动物活体成像
询价

体外透皮实验
1、药物:喷雾、乳膏、溶剂型药物 2、活体皮肤:健康大鼠、小鼠、家兔、豚鼠、裸鼠、小型猪的活体皮肤 3、透皮仪:RYJ-12B透皮仪 4、检测目标:接受液药物浓度、皮内药物滞留、药物渗透速率、表皮残留等 5、参考文献:GB/T 27818—2011《化学品 皮肤吸收 体外试验方法
询价

MC903诱导的特应性皮炎模型
MC903是一种人工合成维生素D3的类似物,广泛用于治疗银屑病,并且能够抑制白血病细胞的增殖分化。 胸腺基质淋巴细胞生成素(TSLP)是一种上皮细胞来源的细胞因子,在起始和促进Th2细胞介导的过敏性炎症中起关键作用, 而MC903能激发小鼠上皮角质细胞高表达TSLP,TSLP通过
地区:苏州工业园区简介:特应性皮炎模型
询价

肝功能衰竭(LF)小鼠模型
原型物种 人 来源 诱发肝衰竭 模式动物品系 SPF级Balb/c小鼠,雄性,周龄为4w~6w,体重为20g-22g。 实验分组 实验分六组:正常对照组、模型组、阳性药组、受试药组三个剂量组。 实验周期 12~14 weeks 建模方法 建模方法: 建立小鼠慢性肝损伤模型:BAL
地区:南京服务名称:技术服务
询价

转基因细胞系建立
1.服务信息 流程分布 周期工作日 提交内容 CRISPR设计 2 专业设计报告 客户确认 1-2 客户回复 引物合成 2 获得引物 载体构建 按实际情况分析 阶段报告 引物测试及目标基因扩增 6 阶段报告 质粒转染细胞 6-8 阶段报告(提供荧光照片) 获得单克隆细胞 35 获
地区:南京提供商:南京尧顺禹
询价

数字PCR服务
数字PCR服务 服务简介 数字PCR技术是继一代普通PCR、二代荧光定量PCR之后的第三代PCR技术。 其原理是将含有核酸分子的反应体系制成成千上万个纳升级的微滴,其中每个微滴不含待检核酸靶分子,或者含有一个至数个待检核酸靶分子,且每个微滴都作为一个独立的PCR反应器,经PCR扩
地区:中国服务名称:数字PCR服务
询价

明场/荧光全景扫描20x/40x
全景扫描 明场200倍/400倍 荧光200倍/400倍 HE/特殊染色/IHC/IF/mIHC/等等 公司介绍 弗瑞思提供组织病理学全套技术服务、病理实验相关的试剂耗材以及开展病理研究相关的培训服务。病理技术服务包括:HE染色,特殊染色,免疫组化,多重免疫组化,多色荧光免疫组化
地区:全国服务名称:明场/荧光全景扫描20x/40x
询价

CRISPR/Cas9 敲除载体库(咨询有优惠)
吉锐生物 CRISPR/Cas9 载体库隆重登场,多种平台供你选择,只有我最懂你!打造不将就的敲除载体库!(☞ 查看载体库详细页) ☞ 还有多种试剂盒可供选择哦~
询价

小动物PET/CT
一、概述 平生公司在国内率先推出了首台小动物PET/CT设备,并拥有全部知识产权。该产品商用化程度高、性能优异,具备国际竞争力,填补了国内空白。 Super Nova® PET/CT:通过对实验动物(大/小鼠及兔子等中小型动物)进行活体状态下的功能及解剖成像,获得动物身体代谢情况
地区:昆山服务名称:小动物PET/CT
询价

BSA性状关联分析
产品简介 混池测序是基于集群分离(Bulked Segregant Analysis,BSA)策略实现对目标性状的定位研究。在分离群体中,通过对发生性状分离的子代个体分别混成两个样本池进行测序,利用高性能计算平台和生物信息学方法,计算影响性状的候选区域以及相应的突变位置和突变类型
询价

免疫电镜技术服务
免疫电镜技术是免疫化学技术与电镜技术结合的产物,是在超微结构水平研究和观察抗原、抗体结合定位的一种方法技术。目前常用的免疫电镜技术分为包埋前免疫电镜技术和包埋后免疫技术,包埋前免疫电镜技术,是先在薄的标本上以直径小于1.4 nm的免疫金标记目的蛋白,银加强放大信号后,以常规电镜的
询价